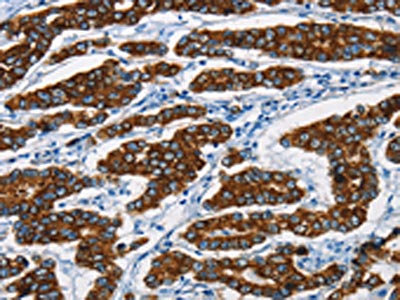

KRT8 Antibody
-
中文名稱:KRT8兔多克隆抗體
-
貨號(hào):CSB-PA579932
-
規(guī)格:¥1100
-
圖片:
-
The image is immunohistochemistry of paraffin-embedded Human gastic cancer tissue using CSB-PA579932(KRT8 Antibody) at dilution 1/20. (Original magnification: ×200)
-
The image is immunohistochemistry of paraffin-embedded Human breast cancer tissue using CSB-PA579932(KRT8 Antibody) at dilution 1/20. (Original magnification: ×200)
-
-
其他:
產(chǎn)品詳情
-
Uniprot No.:
-
基因名:
-
別名:CARD2 antibody; CK 8 antibody; CK-8 antibody; CK8 antibody; CYK8 antibody; CYKER antibody; Cytokeratin endo A antibody; Cytokeratin-8 antibody; DreK8 antibody; EndoA antibody; K2C8 antibody; K2C8_HUMAN antibody; K8 antibody; Keratin 8 antibody; Keratin type II cytoskeletal 8 antibody; Keratin; type II cytoskeletal 8 antibody; Keratin-8 antibody; KO antibody; Krt 2.8 antibody; KRT8 antibody; MGC118110 antibody; MGC174782 antibody; MGC53564 antibody; MGC85764 antibody; sb:cb186 antibody; Type-II keratin Kb8 antibody
-
宿主:Rabbit
-
反應(yīng)種屬:Human,Mouse,Rat
-
免疫原:Fusion protein of Human KRT8
-
免疫原種屬:Homo sapiens (Human)
-
標(biāo)記方式:Non-conjugated
-
抗體亞型:IgG
-
純化方式:Antigen affinity purification
-
濃度:It differs from different batches. Please contact us to confirm it.
-
保存緩沖液:-20°C, pH7.4 PBS, 0.05% NaN3, 40% Glycerol
-
產(chǎn)品提供形式:Liquid
-
應(yīng)用范圍:ELISA,IHC
-
推薦稀釋比:
Application Recommended Dilution ELISA 1:1000-1:2000 IHC 1:25-1:100 -
Protocols:
-
儲(chǔ)存條件:Upon receipt, store at -20°C or -80°C. Avoid repeated freeze.
-
貨期:Basically, we can dispatch the products out in 1-3 working days after receiving your orders. Delivery time maybe differs from different purchasing way or location, please kindly consult your local distributors for specific delivery time.
-
用途:For Research Use Only. Not for use in diagnostic or therapeutic procedures.
相關(guān)產(chǎn)品
靶點(diǎn)詳情
-
功能:Together with KRT19, helps to link the contractile apparatus to dystrophin at the costameres of striated muscle.
-
基因功能參考文獻(xiàn):
- KRT8 mRNA and protein are upregulated in anaplastic thyroid carcinoma. KRT8 protein binds to annexin A2. PMID: 29443941
- K8/K18 variants are overrepresented in Chinese NAFLD patients and might accelerate liver fat storage through insulin resistance. PMID: 28652657
- regulated enhancement of autophagy with concurrent increased expression of KRT8 and the inhibition of KRT8 phosphorylation serve to inhibit oxidative stress-induced epithelial-mesenchymal transitionof retinal pigment epithelium cells. PMID: 28045574
- Histopathological differences between Magnetic resonance-guided high-intensity focused ultrasound (MR-HIFU)-ablated tissue and radiofrequency (RF)-ablated tissue were demonstrated. CK-8 was more reliable for cell viability assessment than H&E when used directly after ablation PMID: 26732321
- Loss of activating transcription factor 3 (ATF3) in knockout mice promotes the emergence of keratins CK5+CK8+ epithelial cells. PMID: 26522727
- notochord-specific marker during early intervertebral disc development PMID: 26910849
- Data show that the filament elongation of both desmin and keratin K8/K18 proceeds very similar to that of vimentin. PMID: 27304995
- New insights into interactions between the nucleotide-binding domain of CFTR and keratin 8. PMID: 27870250
- We present results of a multicentre study measuring UBC((R)) Rapid Test(test that detects fragments of cytokeratins 8 and 18 in urine) in bladder cancer patients and healthy controls with focus on carcinoma in situ (CIS) and high-grade bladder cancer. PMID: 28468590
- Data show that after siRNA transfection, TGF-beta1 protein level was decreased, and CK18 proteins was decreased, while CK8 proteins was increased, and TERT protein expression was slightly increased at 96 h. PMID: 26462837
- The interplay between Solo protein and keratin 8/keratin 18 filaments plays a crucial role in tensile force-induced RhoA activation and consequent actin cytoskeletal reinforcement in endothelial cells. PMID: 26823019
- K8/18 filaments provide resistance to apoptosis in granulosa cell tumor cells by impairing FAS expression. PMID: 26911253
- These metastatic tumors revealed no detectable expression of CK8/18, E-cadherin, VCAM-1, and ICAM-1 PMID: 26847082
- Data show that loss of epithelial membrane protein 2 (EMP2) is involved in sphingosylphosphorylcholine (SPC)-induced phosphorylation of keratin 8 (K8) via ubiquitination of protein phosphatase 2 (PP2A) through alpha4 phosphoprotein by caveolin-1 (cav-1). PMID: 26876307
- The reactivity of rheumatoid arthritis (RA) serum IgG antibodies against K8 was significantly higher than healthy controls and systemic lupus erythematosus patients, confirming K8 as a novel autoantigen of RA. PMID: 26277397
- Variants in highly conserved residues of K8 Lys393Arg (ezetimibe/simvastatin-related) was found in patients with fatal Drug-induced liver injury. PMID: 26286715
- Keratins 8 and 18 are type II acute-phase responsive genes overexpressed in human liver disease. PMID: 24930437
- In human failing myocardium, where TNF-alpha expression is upregulated, K8/K18 were also ectopically expressed PMID: 26280121
- Human KRT8 variants promote acetaminophen induced hepatotoxicity in mouse models. PMID: 25963979
- Syndecan-1 is involved in morphogenesis of the developing tooth crown and cervical loops, andntogether with CK8 and vimentin in differentiation of preameloblasts and preodontoblasts. PMID: 25120060
- K8 immunostaining of tissue from the lymph node metastasis allows defining a sub-group of lymph node-positive breast cancer patients with a highly unfavourable outcome PMID: 25724181
- This is the first time intestinal cells have been suggested also functionally impaired by K8/K18 mutations. PMID: 24915158
- Study indicates that Piwil2 plays a role in Fas-mediated apoptosis and can affect p53 phosphorylation in tumor cells, revealing a novel mechanism of Piwil2 in apoptosis, and supports that Piwil2 plays an active role in tumorigenesis. PMID: 25113562
- An increased expression of cytokeratin 8 and weak of calponin in tunica media of saphenous vein grafts might be useful markers of unfavorable long-term prognosis in CABG patients. PMID: 24338534
- These data support the idea that CK8 is an important receptor for Pet on epithelial cells for starting its cytotoxic effects. PMID: 24327340
- parkin may inhibit cell growth, at least in part, by decreasing RPSA expression and inducing phosphorylation of cytokeratin 8/18 PMID: 23990477
- These findings, along with the emerging role of cell surface CK8 in cancer metastasis, may imply a dual strategy for tumor cell survival in the host. PMID: 24183726
- CK8 up-regulation might have a functional role in HCV infection and pathogenesis, and its ectopic expression induces apoptosis of SMMC7721 cells. PMID: 24115814
- this is the first study to show a down-regulated CK8 expression and the percentage of CK8 positive cell clusters in IDD based upon multiple lines of evidence PMID: 23801880
- Compressive loads resulted in phosphorylation and disassembly of CK8 in nucleus pulposus cells. PMID: 24166186
- A conserved rod domain phosphotyrosine that is targeted by the phosphatase PTP1B promotes keratin 8 protein insolubility and filament organization. PMID: 24003221
- These results indicate the role of K8/18 in modulating invasion in breast cancer. PMID: 23341946
- Report keratin 8 expression in breast papillomas and papillary carcinoma. PMID: 23327593
- K8/18 expression can influence the phenotype of epithelial cancer cells at a transcriptional level and supports the hypothesis that keratins play an active role in cancer progression. PMID: 23449973
- Keratin variants are expressed in a low percentage of patients with alcoholic cirrhosis and do not influence hepatocellular carcinoma development. PMID: 23078008
- There is aberrant expression of CK8 in dysplasia, oral submucous fibrosis, and oral squamous cell carcinoma, suggesting CK8 as a surrogate marker of malignant transformation. PMID: 22677743
- K8 acetylation at Lys-207, a highly conserved residue among type II keratins, is up-regulated upon hyperglycemia and down-regulated by SIRT2. PMID: 23358244
- A key K8/K18 regulation of glucose metabolism in normal and cancerous hepatic cells through differential modulations of mitochondrial hexokinase status and insulin-mediated signaling. PMID: 23164509
- Fibroblasts prepared from different types of malignant tumors stimulate expression of luminal marker keratin 8. PMID: 22270320
- Keratin filaments were assembled from recombinant keratin proteins 8 (K8) and 18 (K18) in the presence of divalent ions (Mg(2+)). PMID: 22853896
- Keratin 8 phosphorylation regulates keratin reorganization and migration of epithelial tumor cells. PMID: 22344252
- Results show K8 is present on the cell surface of transformed prostate cancer cell lines, and K8 increased the activity of plasmin approximately fivefold over a 48-h period. K8 also enhanced the plasmin-mediated proteolysis of vitronectin. PMID: 22354665
- In patients with hemochromatosis, intronic but not exonic K8/K18 variants associate with liver fibrosis development. PMID: 22412904
- We have found the moderate positive correlation between proliferation and a keratin 8 expression in neoplastic epithelial cells. PMID: 22379894
- previously undescribed K8 variants associate with cryptogenic hepatitis in a German cohort of patients, possibly predisposing carriers to the development of liver disease. PMID: 22419260
- Loss of keratin 8 phosphorylation leads to increased oral squamous cell carcinoma progression PMID: 22114688
- Suggest that CK8 is unsuitable for early diagnosis of tongue squamous cell carcinoma. PMID: 21705376
- the mild KRT8 allele is associated with CFTR mediated residual chloride secretion among F508del-CFTR homozygotes PMID: 21548936
- The study demonstrates the strong expression of CK8 in limbal epithelial basal cells, which is maintained during the differentiation and migration of the limbal cells toward the central corneal epithelium. PMID: 20926822
- Clumping factor B is capable of binding cytokeratin 8 during infection. PMID: 20817646
顯示更多
收起更多
-
相關(guān)疾病:Cirrhosis (CIRRH)
-
亞細(xì)胞定位:Cytoplasm. Nucleus, nucleoplasm. Nucleus matrix.
-
蛋白家族:Intermediate filament family
-
組織特異性:Observed in muscle fibers accumulating in the costameres of myoplasm at the sarcolemma membrane in structures that contain dystrophin and spectrin. Expressed in gingival mucosa and hard palate of the oral cavity.
-
數(shù)據(jù)庫(kù)鏈接:
Most popular with customers
-
-
YWHAB Recombinant Monoclonal Antibody
Applications: ELISA, WB, IHC, IF, FC
Species Reactivity: Human, Mouse, Rat
-
Phospho-YAP1 (S127) Recombinant Monoclonal Antibody
Applications: ELISA, WB, IHC
Species Reactivity: Human
-
-
-
-
-